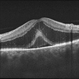
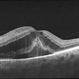

-
 By Virginia Gebhart
By Virginia Gebhart
Retina Consultants of Carolina - Uploaded on Jul 11, 2024.
- Last modified by Joshua Friedman on Jul 12, 2024.
- Rating
- Appears in
- Miscellaneous
- Condition/keywords
- focal chorioretinitis, optic neuritis, FA, fluorescein angiogram (FA), FLUORESCEIN ANGIOGRAPHY
- Photographer
- Virginia Gebhart
- Imaging device
-
Fundus camera
Optos California - Description
- 67 year old female with punched-out CR scars. Hx of laser 3x for apparent peripapillary CNV. ESR, CRP, toxo, IgG/IgM all "normal." Bartonella, quant gold, and FTA-ABS ordered given possibility of neuroretinitis. Vision CF


 Initializing download.
Initializing download.
---thumb.jpg/image-square;max$79,0.ImageHandler)
---thumb.jpg/image-square;max$79,0.ImageHandler)
---thumb.jpg/image-square;max$79,0.ImageHandler)
---thumb.jpg/image-square;max$79,0.ImageHandler)
---thumb.jpg/image-square;max$79,0.ImageHandler)
---thumb.jpg/image-square;max$79,0.ImageHandler)
---thumb.jpg/image-square;max$79,0.ImageHandler)